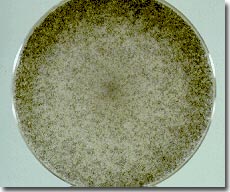

Nấm có thể cho chúng ta biết sự tiến hoá của hai giới?
Nấm không phân chia đực cái rõ ràng nhưng chúng có khác biệt về giới tính. Một phát hiện mới của Trung tâm y tế đại học Duke đã cho biết một số dạng tiến hoá sớm nhất của nấm ẩn chứa những đầu mối tiến hoá giữa hai giới ở động vật bậc cao hơn, trong đó bao gồm cả họ hàng xa của nấm – chính là loài người chúng ta.
Đội nghiên cứu do tiến sĩ Joseph Heitman chỉ đạo đã tách gen quy định giới tính từ một loại nấm cổ xưa nhất được biết đến với cái tên Phycomyces blakesleenus. Kết quả được công bố ngày 10/1/2008 trên tờ Nature.
Nấm không có nhiễm sắc thể giới tính hoàn chỉnh giống như hai nhiễm sắc thể X và Y quy định đặc điểm giới tính ở con người. Thay vào đó, nấm có ADN được gọi là “đoạn phương thức giao phối” có trình tự nhằm xác định giới tính. Đoạn gen quy định phương thức giao phối được phát hiện thấy ở một số loài nấm bậc cao hơn và có tính đa dạng khác thường. Sự khác biệt về đoạn gen này ở những loài nấm cùng họ khiến các nhà khoa học băn khoăn về sự tiến hoá của chúng.
Nhóm nghiên cứu của Heitman đưa ra giải thuyết , thứ tự gen quy định giới tính tìm thấy ở những dạng nấm xuất hiện sớm nhất giúp khám phá cấu trúc cổ xưa của đoạn gen quy định phương thức giao phối và đóng vai trò như một hoá thạch phân tử.
Heitman nói: “Nấm chính là một hệ thống mô hình rất tốt về sự tiến hoá giới tính ở loài người do trình tự gen xác định giới ở loài nấm chính là phiên bản thu nhỏ của vùng quy định giới tính trên nhiễm sắc thể giới tính ở con người”.

Nấm Phycomyces (Ảnh: Wikimedia.org)
Để nhận biết đoạn quy định phương thức giao phối ở loài Phycomyces, các nhà nghiên cứu đã sử dụng máy tính để so sánh đoạn quy định phương thức giao phối trên hệ gen ở một loài nấm khác sau đó so sánh bản đồ gen. Heitman cho biết: “Chúng tôi đã áp dụng phương pháp so sánh protein ở một số loài nấm rồi xác định protein nào xuất hiện ở tất cả các loài”.
Dựa trên cấu trúc của ADN, các nhà khoa học có thể tách biệt hai phiên bản gen quy định giới tính mà họ gọi là sexM và sexP. Loài nấm mang một trong hai gen này có thể giao phối với loài mang gen đối lập còn lại.
Cả hai phiên bản gen sexM và sexP đều mã hoá cho một loại nhóm domain protein có tên gọi HMG (nhóm linh động cao) dẫn đến sự khác biệt về giới tính trong bất cứ một quá trình nào xảy ra. Loại protein này khá tương đồng với một loại protein có tên SRY được mã hoá bởi nhiễm sắc thể Y ở người. Nhiễm sắc thể Y khiến bào thai phát triển giới tính nam. Heitman cho rằng sự tương đồng này chứng tỏ domain protein HMG đã đánh dấu sự khởi đầu cho quá trình tiến hoá giới tính ở cả nấm và con người.
![]() |
Nấm Rhizopus oryzae |
Heitman hy vọng có thể nhận biết được vùng quy định giới tính ở một loài nấm khác có tên Rhizopus oryzae nhằm hiểu sâu hơn về vai trò quy định sự khác biệt giới tính ở nấm của domain protein HMG. Gen của loài Rhizopus có thể đã tiến hoá và biến đổi về mặt hoá học theo một cách mà gen quy định giới tính của loài Phycomyces không thể làm được.
Tiến sĩ Alexander Idnurm, tác giả chính của nghiên cứu mới đây vừa được bổ nhiệm làm trợ lý giáo sư tại đai học Missouri – thành phố Kansas, giải thích: “Loài Rhizopus có thể được dùng để tìm hiểu tác động của một số gen nhất định ở một số loài nấm được biết đến ít hơn theo cách chúng ta dùng chuột thí nghiệm để tìm hiểu tác động của gen ở con người”.
Một bí ẩn gây khó khăn nữa cho Heitman là một số loài nấm mới xuất hiện lại không có domain protein HMG. Ông cho rằng những protein này có thể đã bị thay thế bởi một nhân tố sao chép thay thế nào đó vốn cũng là các protein có thể bật hoặc tắt gen quy định giới tính.
Độc đáo loài xương rồng tự chết để tiếp tục tồn tại và lan rộng khắp sa mạc
Không giống các loại xương rồng khác trên thế giới thường phát triển theo chiều dọc, Creeping Devil phát triển theo chiều ngang và nằm trên mặt đất.
15 loại trái cây được bình chọn ngon nhất thế giới
Chôm chôm, măng cụt, sầu riêng... là những loại trái cây được liệt vào danh sách quý hiếm và ngon nhất thế giới.
Loài sâu róm độc nhất thế giới
Trong các khu rừng nhiệt đới miền Nam Brazil có một loài sâu róm được người dân địa phương gọi là “chú hề lười biếng”, tên khoa học là Lonomia.
Ngắm nghía loài cây "quái vật nước dãi" xanh lè
Trên dãy núi Andes hàng nghìn tuổi tồn tại một loài thực vật có bề ngoài kì lạ đến mức mà có thể khiến chúng ta nhầm tưởng rằng chúng không thuộc về Trái đất này.
Chiêm ngưỡng bông hoa trăm năm mới nở
Một cây họ Dứa cao 12 m trên dãy Andes chỉ nở hoa một lần duy nhất trong suốt thế kỷ.
Sâu bướm Puss: Sát thủ "kịch độc" ẩn mình trong vẻ ngoài dễ thương
Năm ngoái, một cậu bé 7 tuổi từ bang Mississippi (Mỹ) đã bị đốt bởi một trong những con bướm này, và đã nhanh chóng được đưa đến bệnh viện.